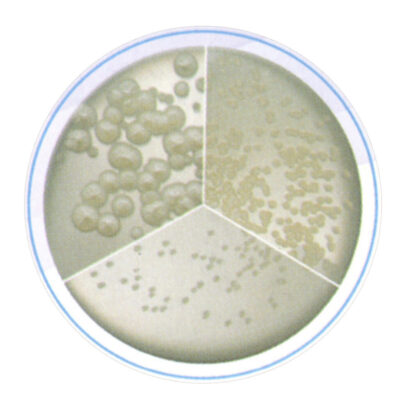
Recuperación de Microorganismos
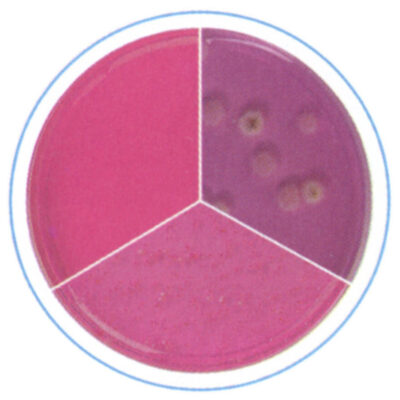
Mohos y Levaduras
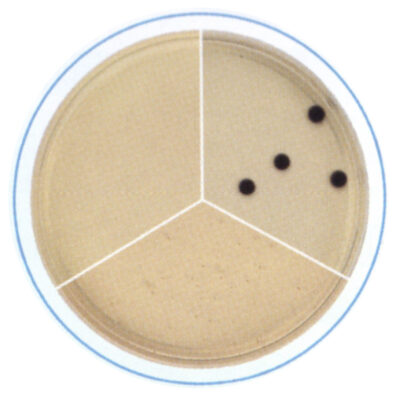
clostridium
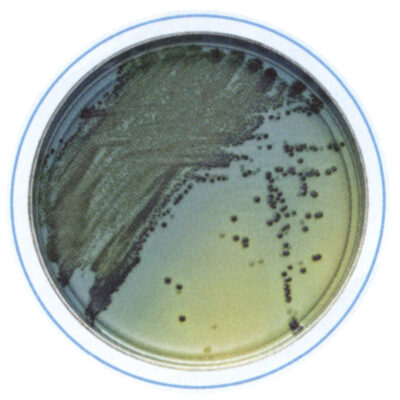
Salmonella
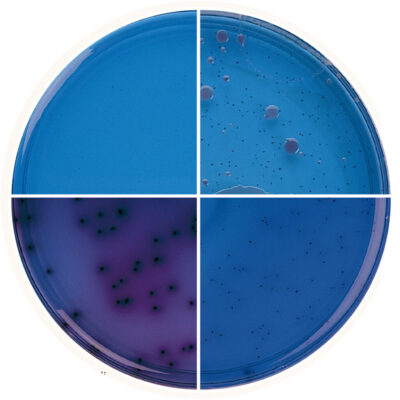
BGA
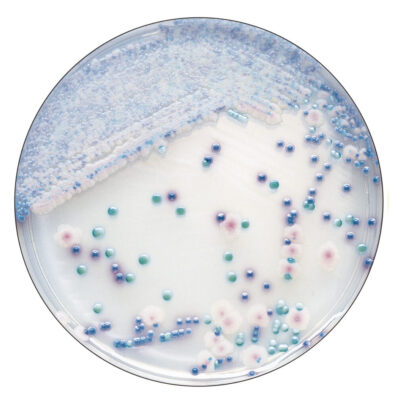
Chromagar

Medios de Cultivo
BD cuenta con una gran variedad de medios deshidratados que cumplen con estándares de desempeño y calidad.
Recuperación de Microorganismos

Coliformes totales y E. coli.
Mohos y Levaduras
Clostridium

S. Aureus
Salmonella

Listeria
Otros medios de cultivo deshidratados
CHROMAgares

Productos de calidad para el rango completo del mercado de Microbiología Industrial, incluyendo:
- Biotecnología
- Cosméticos
- Industria Láctea
- Alimentación/Bebidas
- Industria Farmacéutica
- Vacunas
- Aguas/Aguas Residuales
Nuestros servicios
Nuestros productos cuentan con todos los requerimientos necesarios:
